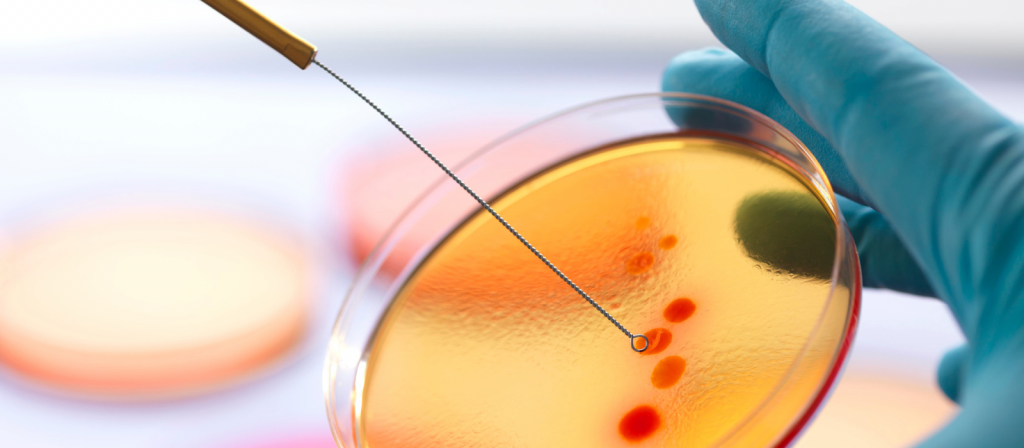

O que é um Esterilizador de Alças com Infravermelho?
Quem trabalha com microbiologia sabe que os meios de cultura são inoculados por alças para microbiologia, as alça para microbiologia podem ser de platina ou podem ser alças descartáveis. O que é um esterilizador de alças infravermelho? Quer saber mais ?
O que é um Esterilizador Infravermelho?
Um esterilizador de alças com infravermelho é um dispositivo utilizado para esterilizar utensílios, especialmente alças de platina. Esse dispositivo utiliza a tecnologia de infravermelho para matar bactérias, vírus e outros microrganismos presentes nos utensílios.
Funciona através da exposição das alças dos utensílios à radiação infravermelha, que tem a capacidade de penetrar nas células dos microrganismos e danificar seu DNA ou RNA, impedindo sua reprodução e, consequentemente, sua sobrevivência.
O Esterilizador de alças com Infravermelho é utilizado para esterilização de alças para microbiologia, pinças e espátulas. É muito útil em ambientes onde o bico de bunsen não é instalado , por exemplo em capelas de fluxo laminar e cabines de segurança biológica.
Seu rápido aquecimento infravermelho e alta temperatura são perfeitos pois aliam praticidade, economia e confiabilidade, esterilizando as alças e espátulas em segundos.
Características Importantes de um Esterilizador Infravermelho
Um esterilizador de alças e pinças para laboratório é um dispositivo utilizado para esterilizar instrumentos de laboratório, como alças bacteriológicas, pinças, espátulas e outros utensílios pequenos. Esses dispositivos são essenciais em ambientes laboratoriais onde a esterilização é crucial para evitar contaminações cruzadas e garantir a precisão dos resultados experimentais.
Os esterilizadores de alças e pinças para laboratório utilizam métodos de esterilização como calor seco, calor úmido (autoclavagem), radiação ultravioleta ou produtos químicos para eliminar microrganismos presentes nos instrumentos. Eles são projetados para fornecer uma esterilização rápida e eficaz, sem danificar os utensílios de laboratório. Esses dispositivos são amplamente utilizados em laboratórios de pesquisa, laboratórios clínicos, indústrias farmacêuticas e em outras áreas onde a esterilização é uma parte fundamental do processo experimental ou de produção.
- Esteriliza alças e agulhas de forma segura e conveniente
- Evita respingos infecciosos e/ou contaminação cruzada
- Proteja o pessoal do laboratório – sem chama aberta – sem gás perigoso
- Ideal para uso em capelas de fluxo laminar

Como funciona um Esterilizador de Alças com Infravermelho?
O esterilizador de alças com infravermelho possui um elemento central sem amianto que usa aquecimento infravermelho para produzir 815°C (1500°F). Esteriliza completamente os microrganismos em 5-7 segundos.
Um Esterilizador de Alças com Infravermelho funciona utilizando a tecnologia de infravermelho para esterilizar as alças de utensílios de cozinha e outros objetos pequenos. O processo é relativamente simples e rápido:
- Exposição às Ondas Infravermelhas: O esterilizador de alças com infravermelho possui uma fonte de luz infravermelha que emite ondas de calor na faixa dos infravermelhos. Quando o utensílio é colocado dentro do esterilizador e a função é ativada, as alças ou objetos a serem esterilizados são expostos diretamente a essas ondas.
- Ação das Ondas Infravermelhas: As ondas de calor infravermelho penetram nas células dos microrganismos presentes nas alças ou utensílios e causam danos ao seu material genético, impedindo sua capacidade de se reproduzir e sobreviver.
- Esterilização Eficiente: O calor gerado pelas ondas infravermelhas é eficaz na eliminação de bactérias, vírus e outros microrganismos que possam estar presentes nas alças dos utensílios. O tempo de exposição necessário para uma esterilização eficiente pode variar de acordo com o dispositivo e as instruções do fabricante.
- Utilização Segura e Conveniente: Os esterilizador com infravermelho são projetados para serem seguros e convenientes de usar. Eles geralmente possuem controles simples e opções de temporizador para facilitar o ajuste do tempo de esterilização. Além disso, muitos modelos são compactos e podem ser facilmente colocados em cozinhas domésticas ou em outros ambientes onde a esterilização é necessária.
Em resumo, o Esterilizador de Alças com Infravermelho é uma opção eficaz para a esterilização de alças de utensílios de cozinha e outros objetos pequenos, utilizando a tecnologia de ondas infravermelhas para eliminar microrganismos e garantir uma maior higiene e segurança no ambiente doméstico ou em outros locais onde é utilizado.
Perguntas Frequentes sobre o esterilizador de alças com Infravermelho
Quais são as principais vantagens do esterilizador de alças com infravermelho?
- Segurança: Não há risco de chamas abertas, tornando-o ideal para ambientes com substâncias inflamáveis.
- Rápido: A esterilização geralmente ocorre em menos de 10 segundos.
- Durável: Menos desgaste de alças e outros instrumentos em comparação com métodos tradicionais de chama.
- Fácil de usar: Basta inserir a alça na câmara para o processo começar automaticamente.
O esterilizador de infravermelho requer manutenção regular?
Sim, recomenda-se a limpeza regular da câmara de aquecimento do esterilizador de alças com infravermelho para evitar o acúmulo de resíduos e a verificação do funcionamento do elemento de aquecimento, garantindo a eficiência contínua do equipamento.
É possível controlar a temperatura de operação?
A maioria dos esterilizadores de alças com infravermelho não possui controle de temperatura, pois eles são projetados para operar a uma temperatura fixa ideal para esterilização. Verifique as especificações do modelo para detalhes.
O esterilizador de infravermelho é adequado para esterilizar outros itens além de alças de inoculação?
Sim, o esterilizador com infravermelho pode ser usado para esterilizar pequenos itens metálicos, como agulhas, bisturis e pinças. No entanto, itens maiores ou feitos de materiais não metálicos podem não ser adequados.
O uso de esterilizador de infravermelho é aprovado para laboratórios microbiológicos?
Sim, é uma alternativa segura e eficaz para laboratórios microbiológicos, pois elimina a necessidade de chama aberta, reduzindo o risco de acidentes e mantendo o ambiente de trabalho mais controlado.
Quais são os cuidados de segurança ao utilizar o esterilizador de alças com infravermelho?
- Não toque na câmara de aquecimento enquanto estiver quente.
- Use pinças ou luvas de proteção ao manusear objetos recém-esterilizados.
- Siga as recomendações do fabricante do esterilizador com infravermelho para evitar superaquecimento ou desgaste prematuro do equipamento.
O esterilizador de infravermelho pode ser usado continuamente durante longos períodos?
Sim, a maioria dos modelos de esterilizador de alças com infravermelho é projetada para uso contínuo em laboratórios com alta demanda. No entanto, é importante seguir as orientações do fabricante sobre tempo máximo de operação e períodos de descanso, se necessário.
Precisando de um esterilizador infravermelho de alças entre em contato com nossa equipe.
AVISO DE DIREITOS AUTORAIS: Todo o material deste blog, sendo proibida toda e qualquer forma de plágio, cópia, reprodução ou qualquer outra forma de uso.
Qualquer dúvida técnica sobre os equipamentos contidos no portfólio SPLABOR, entre em contato com o Departamento de Vendas (sp@splabor.com.br)

A Splabor é uma empresa líder no ramo de fabricação de equipamentos para laboratório, especializada em oferecer uma ampla variedade de equipamentos para laboratórios, materiais e produtos para laboratório de alta qualidade.